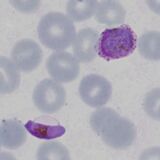

Co-infection with two species
From MalariaETC
Navigation
Main Malaria Index
>RDT main page
>>Single Band Tests
>>>Current page: Co-infection with two species
| Dual species infection
In endemic areas where multiple malarial species circulate estimates of prevalence may be as high as 30%, but in other areas this is far lower and would often be regarded as forming fewer than 5% of infections. Recogition by morphology requires the presence of parasite forms that have recognisable species-specific features for two separate species. This may sometimes be easy, but can be challenging when one species predominates. Some examples are shown below: |